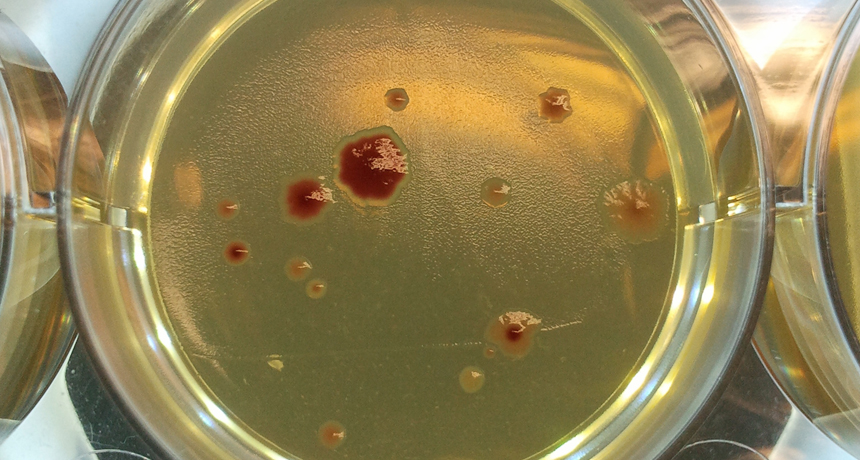

E. coli’s mutation rate linked to cells’ crosstalk
Bacteria resistant to antibiotics (shown) may develop the mutations to resist antibiotics more quickly when they live in a small crowd than when they live in larger groups, a new study suggests.
Rok Krašovec/Univ. of Manchester







